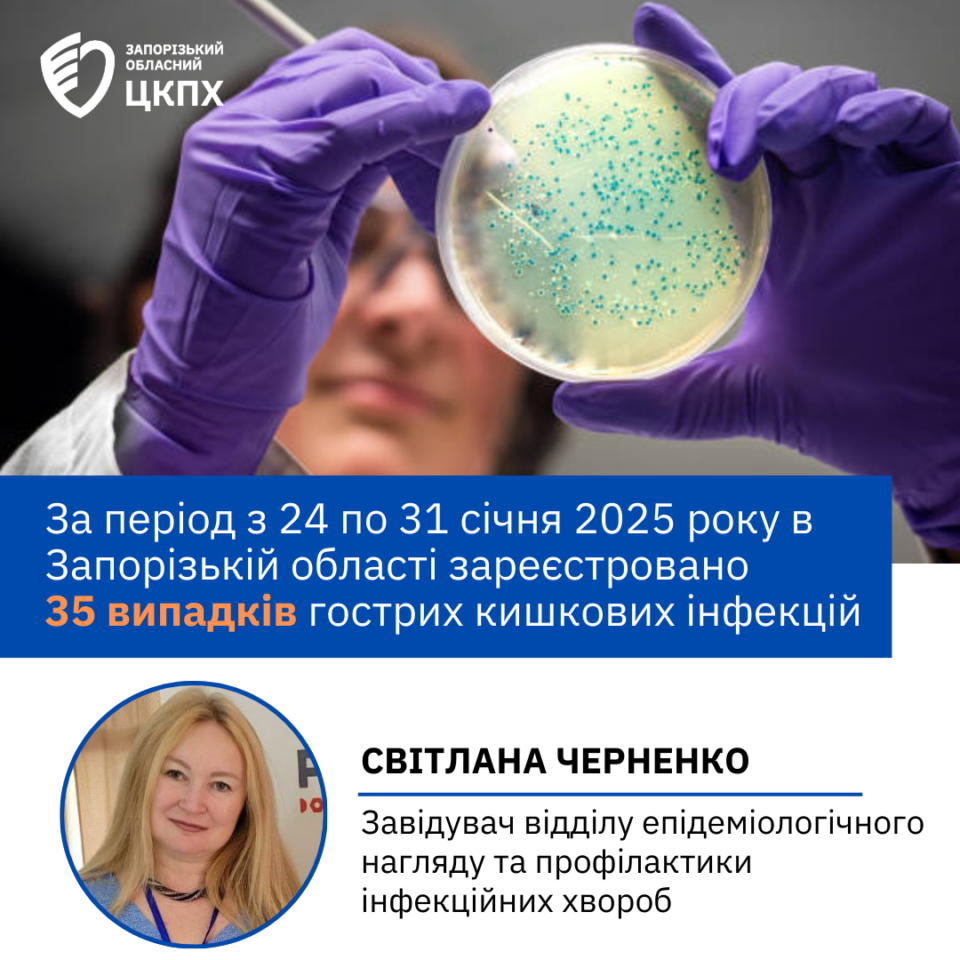

Інформуємо про захворюваність на ГКІ за 5-й тиждень 2025 р.
31 січня 2025
Фахівці відділу епідеміологічного нагляду та профілактики інфекційних хвороб інформують про перебіг захворюваністі на ГКІ за 5-й тиждень 2025 р.
За період з 24.01.2025 по 31.01.2025 року в Запорізькій області зареєстровано 35 випадків гострих кишкових інфекцій, показник – 4,1 на 100 тисяч (на двох попередніх тижнях зареєстровано 37 та 48 випадків відповідно).
Захворюваність ГКІ реєструвалася на трьох адміністративних територіях:
м. Запоріжжя – 29 випадки, показник – 4,08 на 100 тис.;
Запорізький район – 3 випадки, показник – 5,2 на 100 тис.;
Вільнянський район – 3 випадки, показник – 4,7 на 100 тис.
З числа зареєстрованих гострих кишкових інфекцій – 23 випадки серед дітей від 0 до 17 років, у т.ч. серед дітей до року – 5 (на попередньому тижні – 20 випадків, у т.ч. серед дітей до року – 0). Серед тимчасово переміщених осіб зареєстровано – 8 випадків ГКІ (на попередньому тижні – 8).
Всього встановлено факторів передачі – 29, у т.ч. харчовий – 29, з них пов’язані з порушенням правил приготування та зберігання харчових продуктів в домашніх умовах – 25, пов’язані с продуктами, які були придбані на ринках та торгових точках – 4. Серед організованих дітей зареєстровано 2 випадки ГКІ.


